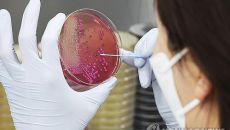

이슈뉴스
-

수도권매립지-광주환경공단, 매립가스 감축 협력
수도권매립지관리공사는 광주환경공단과 매립가스 관리 및 국가 온실가스감축목표(NDC) 달성을 위한 업무협약을 체결했다고 16일- 2025.06.16 16:45
- 머니투데이
-

천안시 '유관순 파크골프장' 개장…36홀 규모
사용 종료된 백석동 위생매립시설 매립장 상부에 조성 [더팩트ㅣ천안=정효기 기자] 충남 천안시는 16일 사용이 종료된 백석동 위- 2025.06.16 16:33
- 더팩트
-

전북서 올해 첫 뎅기열 환자 발생…'해외여행 주의'
전북에서 올해 첫 뎅기열 환자가 발생했습니다. 전북특별자치도 보건환경연구원은 태국 여행을 다녀온 뒤 발진과 발열 등의 증상을- 2025.06.16 16:32
- 연합뉴스TV
-

인천시, 여름철 재난안전 총력 대응…분야별 대책 점검 회의 개최
풍수해, 폭염, 식중독, 수상사고 등 생활 밀착형 안전대책 집중 점검 유정복 시장 “시민 생명과 안전이 최우선” 강조 [더팩트- 2025.06.16 16:29
- 더팩트
-

"게임은 중독물질" 공모전 내건 '게임도시' 성남…논란에 삭제
(서울=연합뉴스) 김주환 기자 = 게임업체가 밀집한 경기 성남시와 산하 위탁기관이 게임을 술, 약물, 도박과 같은 '4대 중독- 2025.06.16 16:06
- 연합뉴스
-

SPC삼립 '윤활유 미스터리'…절삭유 용기에 염화메틸렌 성분표기
(시흥=연합뉴스) 강영훈 권준우 김솔 기자 = 지난달 SPC삼립 시화공장에서 숨진 50대 근로자가 금속 절삭유 용기를 들고 냉- 2025.06.16 16:01
- 연합뉴스
-

SPC삼립 생산라인서 '인체 유해' 절삭유 용기 발견…경찰 수사
(시흥=연합뉴스) 강영훈 권준우 김솔 기자 = 지난달 SPC삼립 시화공장에서 윤활 작업을 하던 근로자가 기계에 끼어 숨지는 사- 2025.06.16 16:01
- 연합뉴스
-

광명시 '재활용품 수집 어르신' 안전보험 지원...경기도 최초
교통사고, 계절성 질환 위험도 높은 재활용품 수집 어르신 대상 안전보험 가입비 전액 지원 부상 진단비·배상책임 최대 500만원- 2025.06.16 15:48
- 머니투데이
-

과천시, 관문체육공원 반려견 놀이터 21일부터 시범 운영
임시 개장 기념 '찾아가는 반려동물 간이 건강검진' 행사 개최 [더팩트|과천=김동선 기자] 경기 과천시는 관문체육공원 내 반려- 2025.06.16 15:40
- 더팩트
-

“DNA 건드리지 않고 질병 원인만 교정” 韓연구진, 차세대 유전자가위 개발 착수
가톨릭중앙의료원이 난치성 신경계 질환 정복을 위한 차세대 RNA(리보핵산) 유전자 편집 기술 개발의 첫 발을 뗐다. 가톨릭중앙- 2025.06.16 15:31
- 서울경제
-

[김준형의 '청맹과니'] 아이보리와 갤럭시
20세기 초, 미국은 산업화가 빠르게 진행되면서, 대규모 기업들이 등장했다. 당연히 많은 노동력이 필요해졌다. 수많은 일자리,- 2025.06.16 15:18
- 메트로신문사
-

양산시 자활기업·사업단, ‘카페나래·카페쉼’ 시설개선
경남 양산시는 자활근로자의 편의 증진, 작업환경개선과 자립 지원을 위해 추진한 자활기업 '카페나래(시청 소통민원실 내)'시설- 2025.06.16 15:14
- 아시아경제
-

"정읍의 진짜 맛집은 여기"…정읍시, 15개 업소 '맛집' 선정
정읍시가 선정한 15개 맛집이 지역 미식 관광의 중심축으로 떠오르고 있다. 인증과 함께 다양한 혜택도 더해져 음식문화 활성화에- 2025.06.16 15:07
- 연합뉴스
-

대덕구노인종합복지관, 노인공익활동사업 '노노케어' 직무교육
[더팩트ㅣ대전=선치영 기자] 사회복지법인 신영복지재단 대덕구노인종합복지관이 16일 대덕구노인종합복지관 2층 대강당에서 노인 일- 2025.06.16 14:47
- 더팩트
-

대전도시공사, 여름철 풍수해 대비 수방자재 점검·장비 훈련 실시
집중호우·태풍 등에 의한 피해 예방과 선제적 대응능력 강화 [더팩트ㅣ대전=선치영 기자] 대전도시공사 환경에너지사업소가 지난 1- 2025.06.16 14:25
- 더팩트
-

과천시, 6월 21일부터 반려견 놀이터 시범 운영
과천시는 오는 6월 21일부터 관문체육공원 내에 조성된 반려견 놀이터를 시범 운영한다고 밝혔다. 반려견 놀이터는 총 400㎡- 2025.06.16 14:19
- 연합뉴스
-

대전보건대 호텔조리·제과제빵학과, 동구행복한어르신복지관에 음식상자 전달
지역사회와 함께하는 나눔 실천…정성 담긴 음식상자로 따뜻한 마음 전해 [더팩트ㅣ대전=선치영 기자] 대전보건대학교가 지난 14일- 2025.06.16 14:14
- 더팩트
-

천안유관순파크골프장 17일 개장...36홀 규모
충남 천안시가 백석동 위생매립시설 상부에 조성한 '천안유관순파크골프장'을 17일부터 내달 14일까지 임시 개장한다. 임시 운영- 2025.06.16 14:02
- 아시아경제
-
횡성군, 식중독 예방 만전…맞춤형 위생 컨설팅·수거검사
(횡성=연합뉴스) 임보연 기자 = 횡성군 보건소는 올여름 식중독 발생 예방을 위해 '2025년 식중독 예방 맞춤형 컨설팅 사업- 2025.06.16 13:56
- 연합뉴스
-

동명대 애견미용행동교정학과-남구청, ‘동숲’서 반려견 위생 미용 봉사
부산시 남구청과 함께하는 반려동물 위생 미용 봉사가 동명대학교 캠퍼스 내에 자리 잡은 반려견 놀이터('동숲')에서 지난 12일- 2025.06.16 13:43
- 아시아경제
-

광명시, 재활용품 수집 어르신 '안정보험' 지원
광명시(시장 박승원)가 거리에서 재활용품을 수집하는 어르신들에게 보다 촘촘한 경제적 울타리를 제공하기 위해 경기도 최초로 '재- 2025.06.16 13:31
- 메트로신문사
-

“내게 언제의 나를 사랑하냐고 물으면 바로 지금”… 혐오 덮은 ‘사랑’ [플랫]
14일 서울 중구 국가인권위원회 인근. 서울 퀴어퍼레이드 참가자들이 행진하자 일부 보수 기독교 신자들이 성소수자 혐오 발언이- 2025.06.16 13:30
- 경향신문
-

경찰, '약물 운전 혐의' 이경규 처방약 국과수 감정 의뢰
도로교통법 위반 혐의로 내사 이경규 측 "공황장애약" 해명 [더팩트ㅣ정인지 기자] 경찰이 약물 운전 혐의를 받는 개그맨 이경규- 2025.06.16 12:51
- 더팩트
-

병원 노동자 10명 중 8~9명 “병원 내 의사 부족”··· “의사 대신 처방·시술도”
의·정 갈등으로 전공의들이 대형병원에서 대거 사직한 지 2년째가 되면서 전체 병원 노동자 10명 중 8~9명이 “의사가 부족하- 2025.06.16 12:35
- 경향신문
-

남원시, 코로나19 재유행…고위험군 '백신접종' 당부
전북 남원시는 최근 인접 국가 홍콩, 중국, 대만 등 코로나19 환자가 증가함에 따라 여름철 코로나19 유행 가능성을 대비해- 2025.06.16 11:53
- 아시아경제

